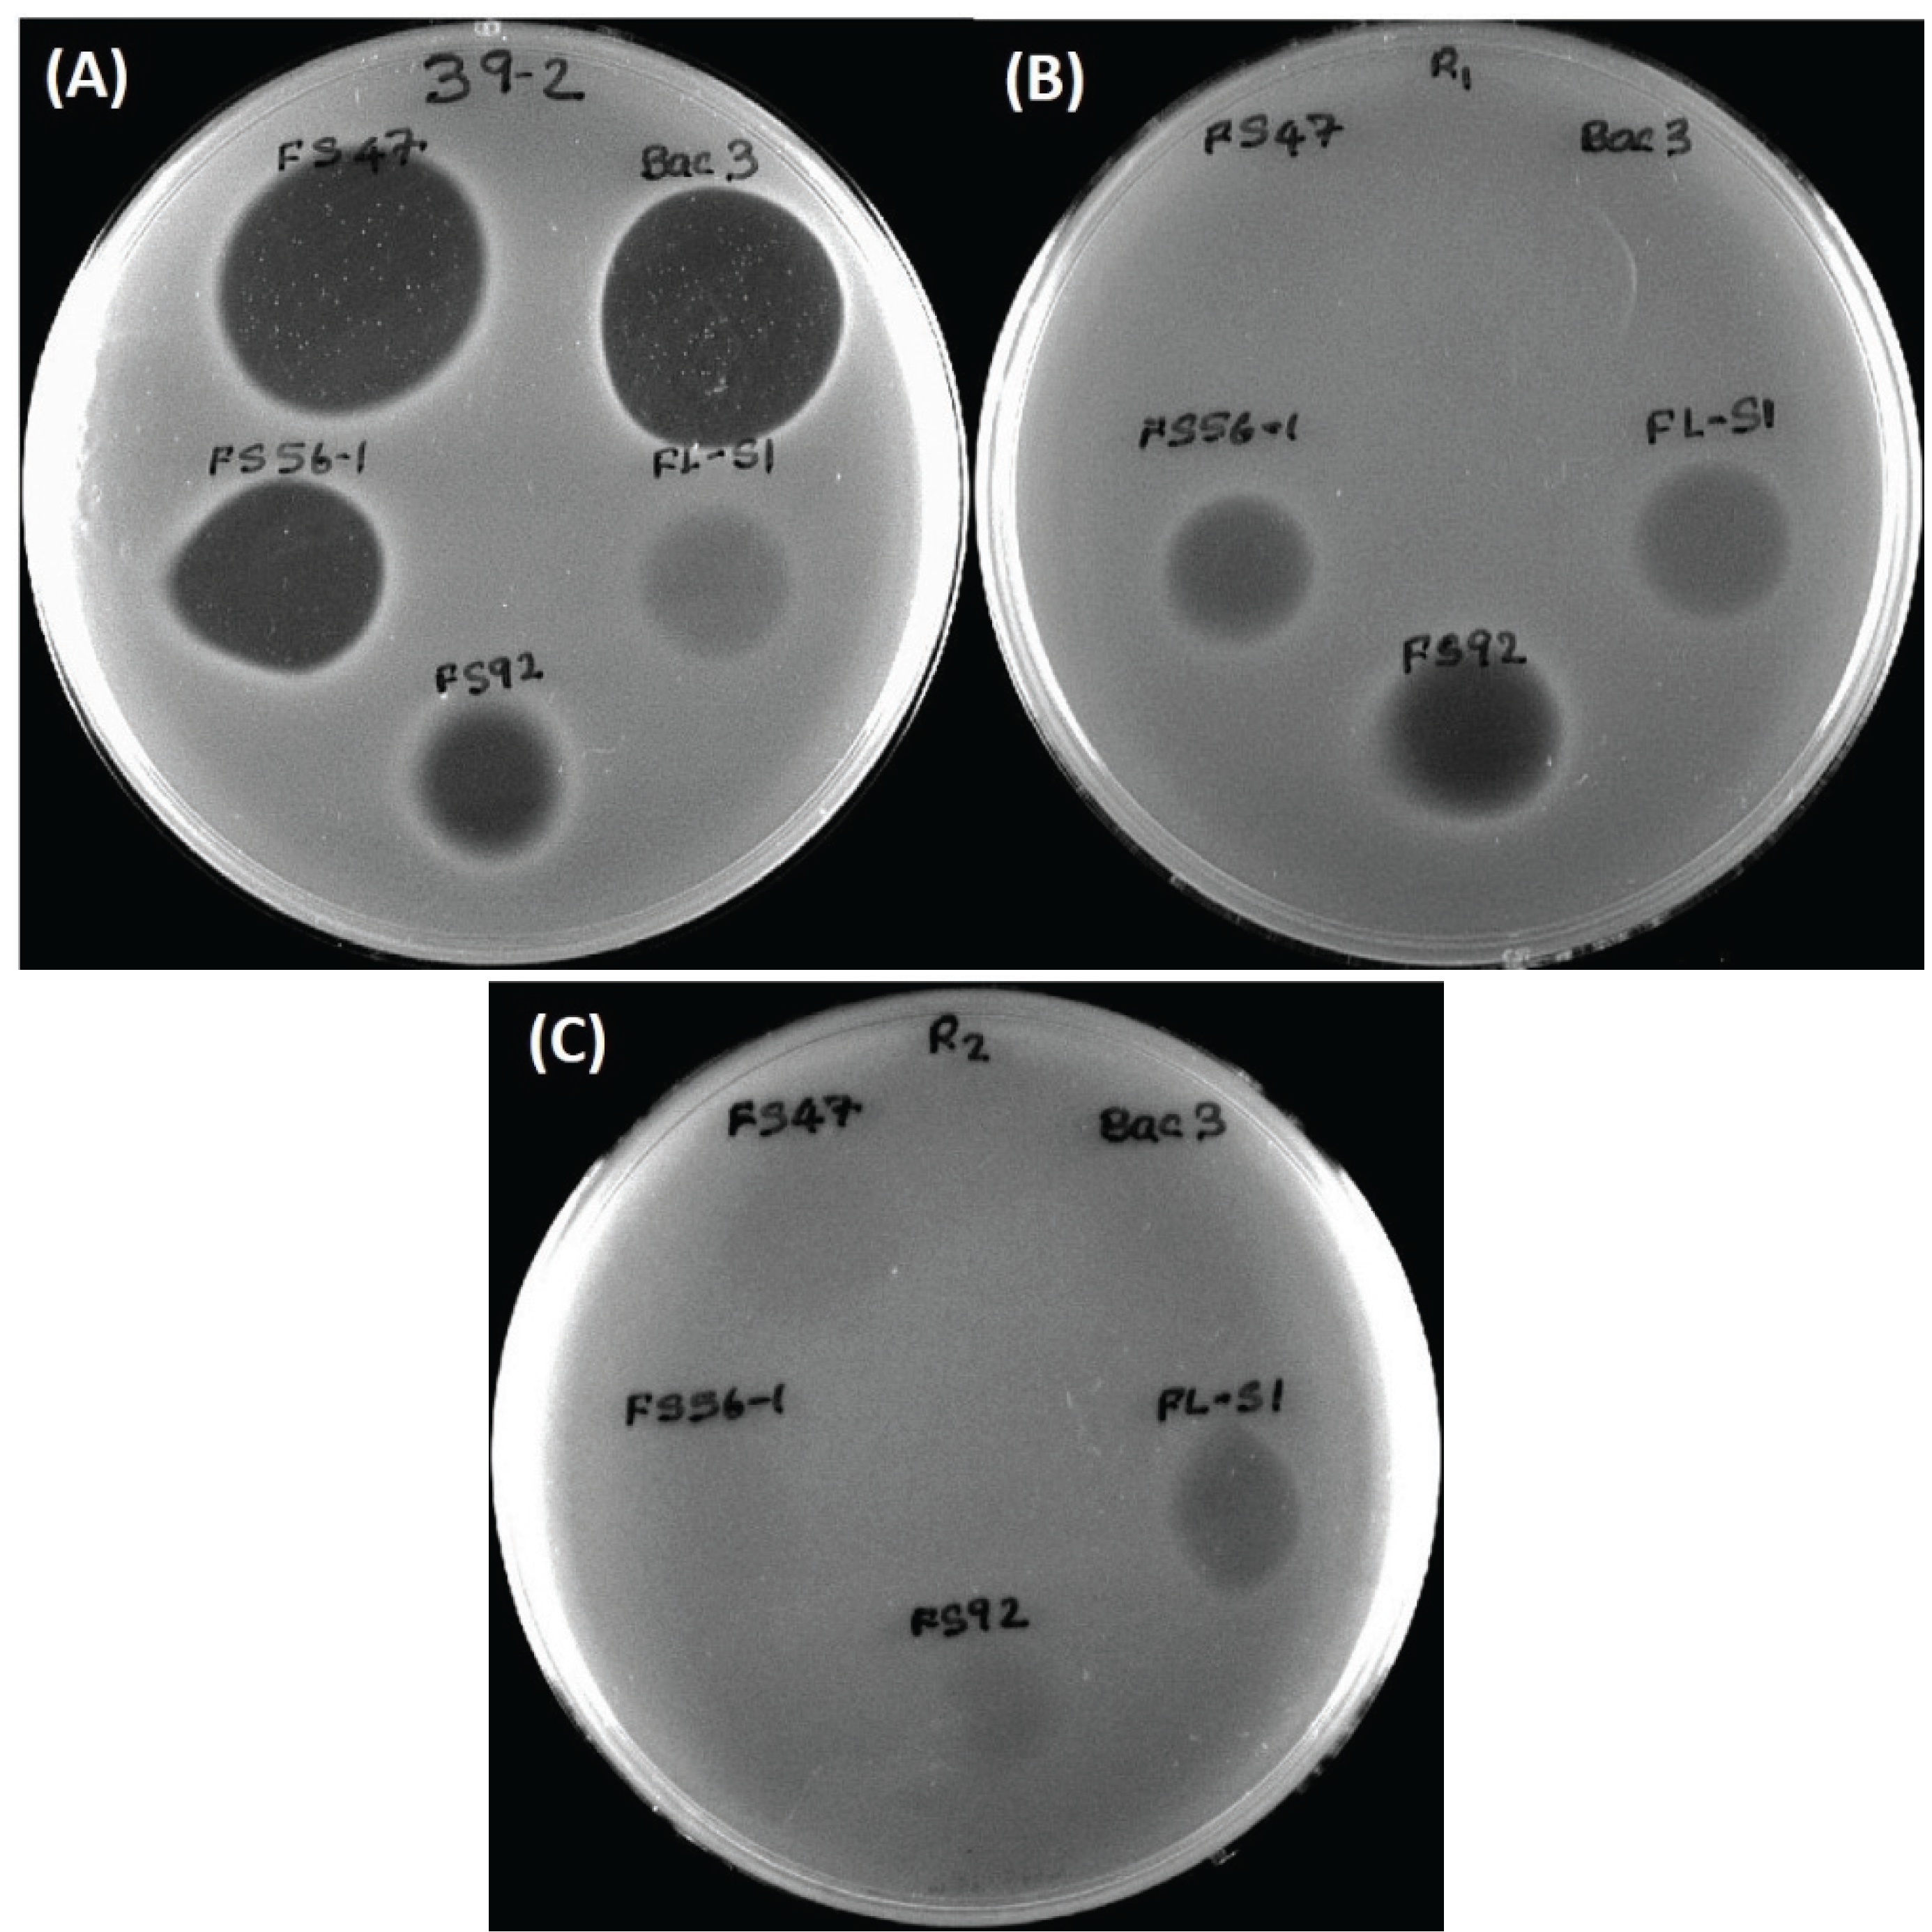

2.2. Bacteriocin Activity at Acid vs. Neutral pH
Nearly all of the Bac
− and Bac
+ cultures lowered the pH of MRS broth (~pH 6.7) down to ~pH 4.3 (
Figure 1B) allowing the use of a standardized neutralization regimen on a fixed volume of cell-free supernatant culture. A pH-effect was observed on bacteriocin activity titers of cell-free supernatants obtained before, and after, pH neutralization in which five of six showed reduced activity after neutralization (
Figure 1C). This might not seem unusual since LAB can produce both lactic acid and bacteriocins, and perhaps neutralization eliminated inhibition due to lactic acid while leaving only bacteriocin activity. However, no inhibitory activity was observed on
Listeria indicator lawns from non-neutralized supernatant from the Bac
− strain,
Lb. delbrueckii 4797-2 (
Figure 1C) and therefore it is not clear why neutralized Bac
+ preps should show changes in inhibitory activity.
Traditional concepts of organic acid inhibition in foods maintains that organic acids, such as lactic acid, are mostly inhibitory to bacteria when the pH of the food medium in which the bacteria are suspended is at or below the pK
a of the acid (
i.e., pH 3.86 for lactic acid). That is when the majority of the lactic acid molecules are nondissociated ([Ac
−H
+]) and able to diffuse into bacterial cells because of their net-neutral charge. When the pH is above the pK
a of the acid, it is mostly in the dissociated form ([Ac
−] + [H
+]) and the charge on the lactate anion prevents its entry into cells (or after the nondissociated form gains entry into cells, it dissociates to the toxic anion form in the neutral pH of the bacterial cytoplasm). In the current study the pH of the Bac
− spent broth (and five of six Bac
+ preps) was at ~pH 4.37 and above the pK
a of lactic acid and showed no inhibitory activity on agar when applied to lawns of
L. monocytogenes 39-2 indicator cells (
Figure 1C and
Figure 2).
A possible explanation of the pH-related phenomena observed in this study is that the net charge of the bacteriocin is also involved in adsorption to cell surfaces of Gram-positive bacteria. Most bacteriocins have higher antimicrobial activity at pH 5 or lower, compared to their activity at physiological pH [
11,
12,
13]. At pH 6 or above, bacteriocin molecules adsorb to the surface of bacteriocin producer cells and other Gram-positive bacteria, in effect, titering them out of solution [
7,
12,
14,
15,
16,
17]. In general, at low pH, bacteriocins do not adsorb well to bacterial cells, so more is available for inhibitory functionality and increased antibacterial activity is observed. When culture supernatants are neutralized, activity due to acid is eliminated, but bacteriocin activity is also diminished because of this absorption phenomenon.
Figure 1.
Treatment of culture supernatants produced by Lb. delbrueckii 4797-2 (Bac−) and Bac+ strains: Lb. curvatus FS47, P. acidilactici Bac3, Lb. curvatus Beef3, En. faecium FS56-1, En. thailandicus FS92, and Lc. lactis FLS1. (A) Comparison of bacteriocin activity after filter sterilization or heat pasteurization; (B) The pH of MRS broth media before inoculation and after overnight growth of various strains used in this study; (C) Bacteriocin activity titers of cell-free supernatants against L. monocytogenes 39-2, before and after neutralization. Treatments with the same culture supernatant that have different lower case letters are significantly different (p < 0.05); treatments with the same lowercase letter are not significantly different (p > 0.05). No differences were found in duplicate replications of samples in (A) and (C).
Figure 1.
Treatment of culture supernatants produced by Lb. delbrueckii 4797-2 (Bac−) and Bac+ strains: Lb. curvatus FS47, P. acidilactici Bac3, Lb. curvatus Beef3, En. faecium FS56-1, En. thailandicus FS92, and Lc. lactis FLS1. (A) Comparison of bacteriocin activity after filter sterilization or heat pasteurization; (B) The pH of MRS broth media before inoculation and after overnight growth of various strains used in this study; (C) Bacteriocin activity titers of cell-free supernatants against L. monocytogenes 39-2, before and after neutralization. Treatments with the same culture supernatant that have different lower case letters are significantly different (p < 0.05); treatments with the same lowercase letter are not significantly different (p > 0.05). No differences were found in duplicate replications of samples in (A) and (C).
Figure 2.
(A) Inhibition of L. monocytogenes 39-2 by overlay of prior spotted and incubated culture spots (“deferred antagonism”). Spotted cultures, clockwise from top: Lb. delbrueckii 4797-2 (Bac− control), Lb. curvatus FS47, En. faecium FS56-1, Pediococcus acidilactici Bac3, Lactococcus lactis FS91-1, En. thailandicus FS92, En. faecium FS97-2; (B) Inhibition of L. monocytogenes indicator lawn spotted with non-neutralized cell free spent broth from Bac+ (Lb. curvatus FS47) and Bac− (Lb. delbrueckii 4797-2) strains (“concurrent antagonism”). The presence of “spontaneous resistant” indicator colonies can be clearly observed in the curvaticin FS47 inhibition zone.
Figure 2.
(A) Inhibition of L. monocytogenes 39-2 by overlay of prior spotted and incubated culture spots (“deferred antagonism”). Spotted cultures, clockwise from top: Lb. delbrueckii 4797-2 (Bac− control), Lb. curvatus FS47, En. faecium FS56-1, Pediococcus acidilactici Bac3, Lactococcus lactis FS91-1, En. thailandicus FS92, En. faecium FS97-2; (B) Inhibition of L. monocytogenes indicator lawn spotted with non-neutralized cell free spent broth from Bac+ (Lb. curvatus FS47) and Bac− (Lb. delbrueckii 4797-2) strains (“concurrent antagonism”). The presence of “spontaneous resistant” indicator colonies can be clearly observed in the curvaticin FS47 inhibition zone.
2.3. Wild-Type L. monocytogenes 39-2 (R0) and Bacteriocin-Resistant Variants (R1, R2)
A bacteriocin-resistant variant of the wild-type
L. monocytogenes 39-2 (“R0”;
i.e., not resistant) obtained against curvaticin FS47 was designated “R1” (
i.e., resistant #1). A comparison of inhibitory bacteriocin spots on lawns of
L. monocytogenes R0 and R1 demonstrated that the spontaneous resistance against
Lb. curvatus bacteriocin FS47 gave cross-resistance to
P. acidilactici bacteriocin Bac3 (
Figure 3) and
Lb. curvatus bacteriocin Beef3 [
18]. Some bacteriocins no longer inhibited
L. monocytogenes 39-2 (R1) while others were still inhibitory to it (
Figure 3B). The different bacteriocins whose activity were no longer inhibitory to the R1 Bac
R variant (
i.e., FS47, Bac3, and Beef3) were classified as having the same MOA while those that were still inhibitory to R1 (
i.e., FS56-1, FS92) were considered to possess another MOA. This process was again repeated by isolating additional enterocin FS56-1 Bac
R mutants against R1 that possessed accumulated bacteriocin resistances, now designated “R2” (
Figure 3C). Activity against R2 identified a bacteriocin (
i.e., FLS1) of still another MOA (
Figure 3C). The wild type
L. monocytogenes (R0) and its two consecutively-derived Bac
R variants (R1, R2) were used as indicator organisms to screen for new Bac
+ isolates as well as screen bacteriocin preparations in microplate inhibition assays [
19].
Figure 3.
(A) L. monocytogenes 39-2 (R0) spotted with cell free supernatants from five Bac+ strains: Lb. curvatus FS47, P. acidilactici Bac3, Lactococcus lactis FLS1, En. thailandicus FS92, En. faecium FS56-1; (B) L. monocytogenes 39-2 (R1) spotted with the same five Bac+ supernatants; (C) L. monocytogenes 39-2 (R2) spotted with the same five Bac+ supernatants.
Figure 3.
(A) L. monocytogenes 39-2 (R0) spotted with cell free supernatants from five Bac+ strains: Lb. curvatus FS47, P. acidilactici Bac3, Lactococcus lactis FLS1, En. thailandicus FS92, En. faecium FS56-1; (B) L. monocytogenes 39-2 (R1) spotted with the same five Bac+ supernatants; (C) L. monocytogenes 39-2 (R2) spotted with the same five Bac+ supernatants.
2.4. Microplate Growth Inhibition Assays Using Wild-Type L. monocytogenes 39-2 (R0)
Differences were observed with Bac
− preps in microplate growth inhibition assays in which
L. monocytogenes 39-2 (R0) was treated with neutralized or non-neutralized cell-free culture supernatants (
Figure 4) that were not observed during agar spot activity titer assays (
Figure 1C). When non-neutralized cell-free supernatants of the Bac
− control strain (
Lb. delbrueckii 4797-2) were added to
L. monocytogenes R0, some inhibition was observed whereby R0 did not grow as well as in the Bac
− control assay while all the Bac
+ preparations showed baseline-level inhibition (
Figure 4A). However, when neutralized cell-free supernatants of the Bac
− 4797-2 strain were added to R0, it grew equally well and without any significant difference from the R0 control (
Figure 4B). Trials with the neutralized preps also showed late recovery of
L. monocytogenes R0 treated with the Beef3 Bac
+ prep (
Figure 4B) suggesting possible outgrowth of spontaneous resistant variants which is consistent with observations in the agar spot assay for FS47 (
Figure 2B) and other bacteriocins (
Figure 3A). The baseline-level inhibition of
L. monocytogenes by bacteriocin Beef3 observed with non-neutralized preparations (
Figure 4A) could have been due to acid-assisted inhibition that was removed by neutralization; such differences are likely only noticeable with microplate growth inhibition data, offering real-time growth curve comparisons, that would otherwise appear as similar fully-grown endpoints on agar surface spot assays.
Figure 4.
Microplate growth inhibition assays showing the activity of Listeria monocytogenes 39-2 (R0) treated with culture supernatants from: None (R0 Cont.), Lb. delbrueckii 4797-2 (Bac−), Lb. curvatus FS47, P. acidilactici Bac3, Lb. curvatus Beef3, En. faecium FS56-1, En. thailandicus FS92, and Lc. lactis FLS1. (A) Microplate assay using non-neutralized culture supernatants; (B) Microplate assay using neutralized culture supernatants. Data points represent the means of triplicate replications and error bars represent the standard deviations from the means (error bars were not used for all curves in order to prevent clutter). Treatments with different lowercase letters are significantly different (p < 0.05); letters in brackets are for entire group of graph lines.
Figure 4.
Microplate growth inhibition assays showing the activity of Listeria monocytogenes 39-2 (R0) treated with culture supernatants from: None (R0 Cont.), Lb. delbrueckii 4797-2 (Bac−), Lb. curvatus FS47, P. acidilactici Bac3, Lb. curvatus Beef3, En. faecium FS56-1, En. thailandicus FS92, and Lc. lactis FLS1. (A) Microplate assay using non-neutralized culture supernatants; (B) Microplate assay using neutralized culture supernatants. Data points represent the means of triplicate replications and error bars represent the standard deviations from the means (error bars were not used for all curves in order to prevent clutter). Treatments with different lowercase letters are significantly different (p < 0.05); letters in brackets are for entire group of graph lines.
2.5. Microplate Assay of Bacteriocin Preparations vs. L. monocytogenes 39-2 (R1)
Microplate inhibition assays were also performed with the
L. monocytogenes 39-2 R1 Bac
R variant (
Figure 3B) and growth inhibition assays were again evaluated with non-neutralized and neutralized cell-free culture supernatants (
Figure 5). As observed previously, the R1 strain with non-neutralized supernatants from the Bac
− control strain showed intermediate inhibition (
Figure 5A) whereby the neutralized supernatants from the Bac
− control showed no inhibition (
Figure 5B). This time, three of six neutralized Bac
+ preps showed no inhibition of R1 due to the bacteriocin resistance incurred by strain R1 (
Figure 5B). All of the bacteriocins that are no longer inhibitory to
L. monocytogenes 39-2 (R1) are presumed to have the same or highly similar MOA while those bacteriocins that were still inhibitory to R1 were considered to have a different MOA. The data obtained in microplate growth assays with
L. monocytogenes 39-2 (R1) suggests that curvaticin FS47, curvaticin Beef3, and pediocin Bac3 belong to the same mode of action, MOA1.
2.6. Microplate Assay of Bacteriocin Preparations vs. L. monocytogenes 39-2 (R2)
Similar to the results of the inhibition assays against
L. monocytogenes 39-2 R0 and R1 performed with non-neutralized culture supernatants, we observed full growth of
L. monocytogenes 39-2 (R2), partial inhibition of R2 by the Bac
− supernatants, and full inhibition from the Bac
+ supernatants (
Figure 6A). When the neutralized cell-free supernatants were added, the R2 Bac
R variant showed the same resistance to bacteriocins FS47, Bac3, and Beef3 as R1, but less sensitivity to enterocins FS92 and FS56-1, from which R2 was selectively derived (
Figure 6B). The remaining Bac
+ prep (FLS1) still showed baseline-level inhibition of R2 (
Figure 6B). From these data, we suggest that enterocins FS92 and FS56-1 belong to a second mode of action, MOA2, while lacticin FLS1 belongs to a third, MOA3.
These data support that the microplate inhibition assay is more sensitive to acid than the agar spot assays, presumably because of the scale of inhibitory assay applied whereby only 5–10 μL of supernatant is applied as a spot on the agar surface allowing the agar layer below the spot to buffer the acid. In the microplate assay, half of the liquid added to the wells is culture supernatant and background lactic acid may have more influence than in the agar spot assays. The microplate assay allows the observation of discernible inhibition during growth using turbidity data over time. Growth curves of neutralized preparations that appear delayed are likely inhibited to some degree, and may represent unique MOAs that are not readily discernible by the agar plate assay. It is also noteworthy that some bacteriocinogenic strains, including FS56-1 and FS92, have been shown to possess more than one bacteriocin [
19,
20]. It is reasonable to assume that in such situations, if one bacteriocin is rendered insensitive by a bacteriocin-resistance indicator, but not the other, it is possible that a reduced zone size may be observed in spot on lawn assays (
Figure 3B) or intermediate results in microplate growth assays (
Figure 6B). Further testing is needed to confirm these hypotheses. Although baseline-level inhibition is always ideal and preferable, bacteriocins that show inhibitory activity at levels between full baseline inhibition and uninhibited growth may still have merit in food applications, especially when using mixtures of bacteriocins of different MOAs.
Figure 5.
Microplate growth inhibition assays showing the activity of Listeria monocytogenes 39-2 (R1) treated with culture supernatants from: None (R1 Cont.), Lb. delbrueckii 4797-2 (Bac−), Lb. curvatus FS47, P. acidilactici Bac3, Lb. curvatus Beef3, En. faecium FS56-1, En. thailandicus FS92, and Lc. lactis FLS1. (A) Microplate assay using non-neutralized culture supernatants; (B) Microplate assay using neutralized culture supernatants. Data points represent the means of triplicate replications and error bars represent the standard deviations from the means (error bars were not used for all curves in order to prevent clutter). Treatments with different lowercase letters are significantly different (p < 0.05); letters in brackets are for entire group of graph lines.
Figure 5.
Microplate growth inhibition assays showing the activity of Listeria monocytogenes 39-2 (R1) treated with culture supernatants from: None (R1 Cont.), Lb. delbrueckii 4797-2 (Bac−), Lb. curvatus FS47, P. acidilactici Bac3, Lb. curvatus Beef3, En. faecium FS56-1, En. thailandicus FS92, and Lc. lactis FLS1. (A) Microplate assay using non-neutralized culture supernatants; (B) Microplate assay using neutralized culture supernatants. Data points represent the means of triplicate replications and error bars represent the standard deviations from the means (error bars were not used for all curves in order to prevent clutter). Treatments with different lowercase letters are significantly different (p < 0.05); letters in brackets are for entire group of graph lines.
Figure 6.
Microplate growth inhibition assays showing the activity of Listeria monocytogenes 39-2 (R2) treated with culture supernatants from: None (R2 Cont.), Lb. delbrueckii 4797-2 (Bac−), Lb. curvatus FS47, P. acidilactici Bac3, Lb. curvatus Beef3, En. faecium FS56-1, En. thailandicus FS92, and Lc. lactis FLS1. (A) Microplate assay using non-neutralized culture supernatants; (B) Microplate assay using neutralized culture supernatants. Data points represent the means of triplicate replications and error bars represent the standard deviations from the means (error bars were not used for all curves in order to prevent clutter). Treatments with different lowercase letters are significantly different (p < 0.05); letters in brackets are for entire group of graph lines.
Figure 6.
Microplate growth inhibition assays showing the activity of Listeria monocytogenes 39-2 (R2) treated with culture supernatants from: None (R2 Cont.), Lb. delbrueckii 4797-2 (Bac−), Lb. curvatus FS47, P. acidilactici Bac3, Lb. curvatus Beef3, En. faecium FS56-1, En. thailandicus FS92, and Lc. lactis FLS1. (A) Microplate assay using non-neutralized culture supernatants; (B) Microplate assay using neutralized culture supernatants. Data points represent the means of triplicate replications and error bars represent the standard deviations from the means (error bars were not used for all curves in order to prevent clutter). Treatments with different lowercase letters are significantly different (p < 0.05); letters in brackets are for entire group of graph lines.
Another observation in the study was the tailing of most of the growth curves in the microplate assays (
Figure 4,
Figure 5 and
Figure 6). Although the reason was not ascertained, it is likely due to a slow lysis of the bacterial cells as bacteriocins form membrane pores in susceptible cells and/or the result of a change in cellular morphology upon nutrient depletion during extended stationary phase which may have an effect on optical density.
Figure 5B with error bars has been published as an
Appendix Figure A1; likewise,
Figure 6B with error bars has been published as an
Appendix Figure A2.